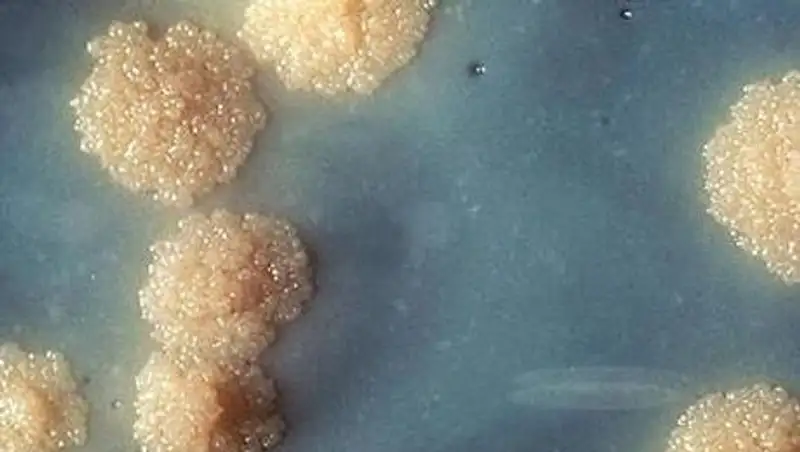

Диагноз «сибирская язва» в ЮКО у забитого скота не подтвердился
Zakon.kz
Zakon.kz
Споры сибирской язвы не были обнаружены ни у людей, ни в самом мясе животного.
Диагноз «сибирская язва» в ЮКО у забитого скота не подтвердился, сообщает КазИнформ.
Как рассказала на брифинге главный специалист департамента по защите прав потребителей Балкумыс Мусаева, споры сибирской язвы не были обнаружены ни у людей, ни в самом мясе животного.
«Ткань болячек госпитализированных мужчин и мяса забитой коровы взяли на анализ. Споры сибирской язвы не были обнаружены. Но 30 человек, которые успели купить мясо, взяли под контроль», - рассказала Балкумыс Мусаева.
За состоянием контактных лиц врачи будут наблюдать 10 дней. Дело в том, что инкубационный период болезни может длиться 8 дней. Напомним, в селе Алпамыс Сарыагашского района шесть человек участвовали при забое скота. После этого у двоих на руках появились язвы. Один из них пытался лечиться самостоятельно, но потом все же решил обратиться к врачам. Язвы - это главный симптом сибирской язвы, а потому их госпитализировали.
Южно-Казахстанская область считается неблагополучной по сибирской язве. Последний случай заражения был в 2011 году. Тогда заболели 3 жителя Ордабасинского района. Летальных случаев нет.
Светлана Курносова
Поделитесь новостью
Читайте также
Если вы видите данное сообщение, значит возникли проблемы с работой системы комментариев. Возможно у вас отключен JavaScript












